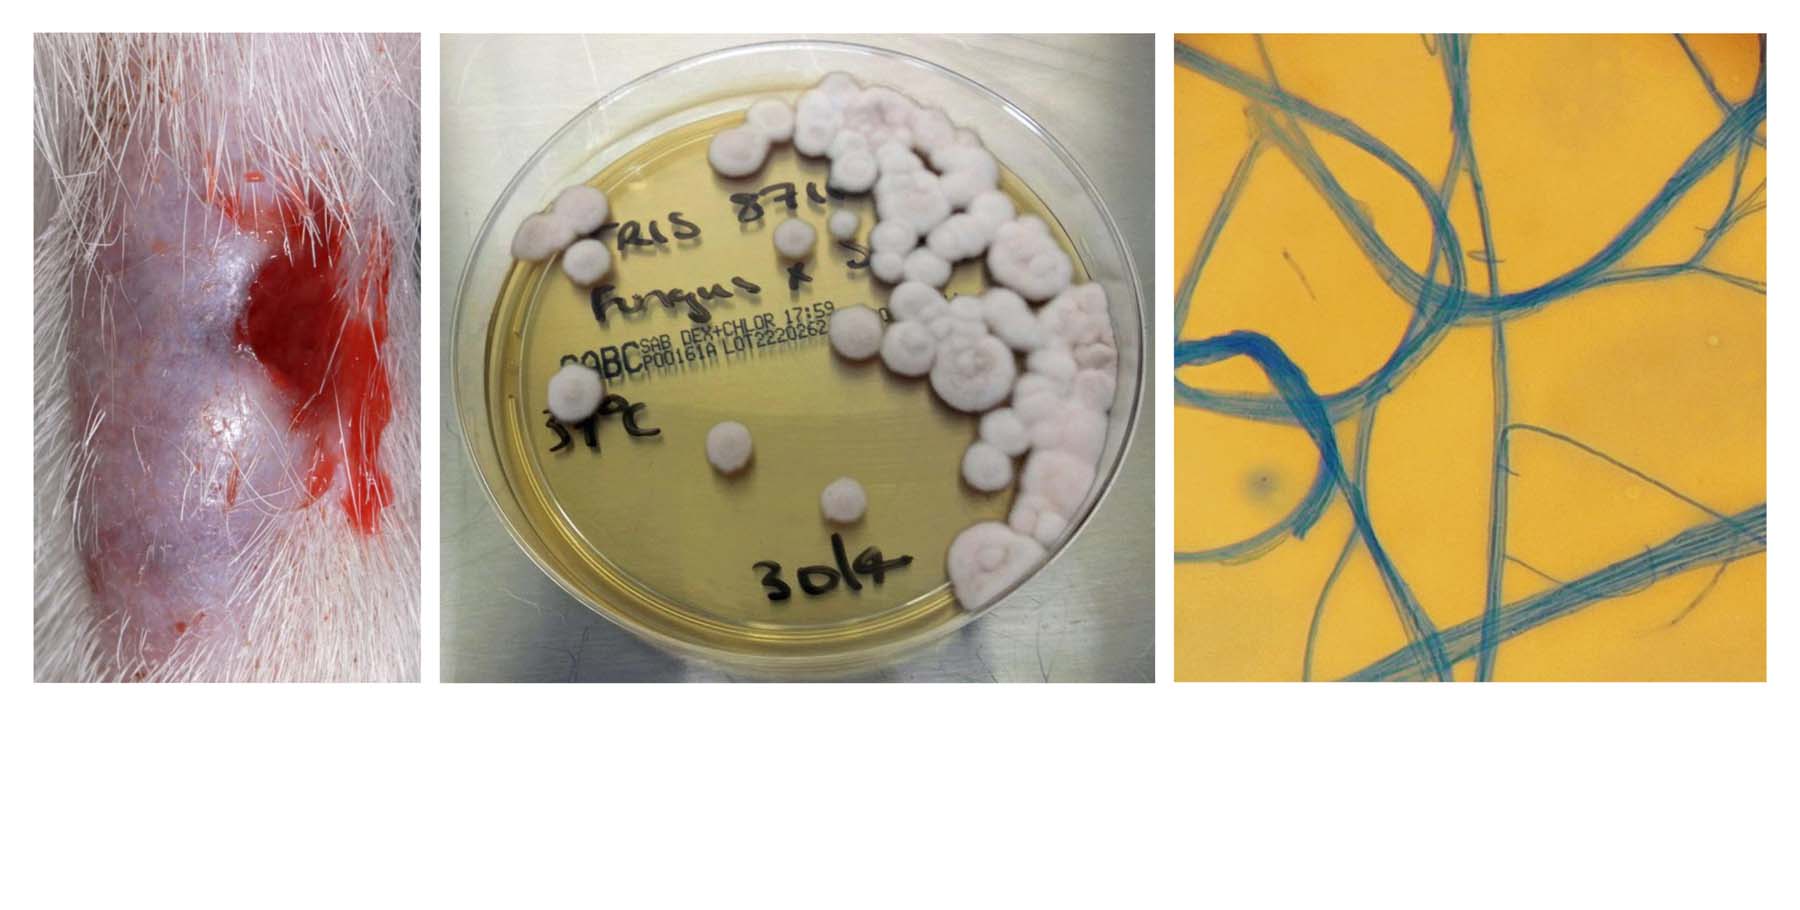
Phaeohyphomycosis: Chronic, Ulcerated, Fungal Granuloma on a Cat's Tail (Alternaria infectoria): Diagnostic Culture & Stained Fungal Hyphae

Phaeohyphomycoses and hyalohyphomycoses are rare opportunistic infections acquired from the environment. More cases have been reported in recent years in humans and cats.
Single or multiple nodules or ulcerated plaques in the skin are the typical lesions. In some cases the infection disseminates internally.
Diagnosis is based on fungal detection by cytology which, as in all the cases shown above, was made immediately on first consultation. Rapid further investigation was recommended to include imaging (dedicated dermatological histopathology with ultrasound, radiography and/or CT). Fresh frozen tissue sampling, during these initial investigation, then allowed subsequent specialised culture to provide definitive diagnosis and species identification. This allowed more definitive surgical and medical treatment alongside more informed prediction of prognosis.
Treatment often involves surgical excision, or amputation if possible, in cases of localised skin disease followed by systemic antifungal therapy, with agent of first choice depending on all important culture results. Relapses after treatment are common especially when diagnosis was delayed. The prognosis is guarded to poor in cats with multiple lesions and systemic or neurological involvement.
There is thought to be no zoonotic risk associated with contact with infected cats.
Evidence-based guidelines have been written by an international group of specialists with the aim to provide veterinarians with current recommendations for the diagnosis and treatment of fungal granulomas:
Lloret A, Hartmann K, Pennisi M G et al (2013) Rare opportunistic mycoses in cats: phaeohyphomycosis and hyalohyphomycosis: ABCD guidelines on prevention and management. J Feline Med Surg 15 (7), 628-630 DOI: 10.1177/1098612X13489227
Here is a link to very useful resource: Dr Fungus.org Click Here To Access